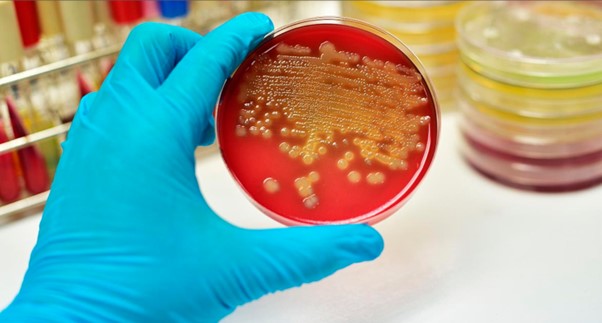
Анализ кала: что может показать?

Анализ кала – это важное диагностическое исследование, которое может многое рассказать о состоянии здоровья человека. Через анализ кала можно выявить множество различных заболеваний и нарушений в работе желудочно-кишечного тракта. Понимание того, что именно может показать этот анализ, помогает в своевременном обнаружении проблем и начале лечения.
Какие проблемы может выявить анализ кала?
-
Нарушения пищеварения
-
Непереваренные частицы пищи в кале могут указывать на недостаточное выделение ферментов поджелудочной железой или другие проблемы с пищеварением.
-
-
Инфекции кишечника
-
Присутствие определенных бактерий, вирусов или паразитов, выявляемых при микробиологическом анализе, может указывать на инфекционные заболевания, такие как сальмонеллез или амебиаз.
-
-
Воспалительные заболевания кишечника
-
Заболевания, такие как болезнь Крона или язвенный колит, могут быть диагностированы через наличие в кале повышенного количества лейкоцитов и других маркеров воспаления.
-
-
Наличие крови
-
Скрытая кровь в кале может быть признаком геморроя, трещин, полипов, колоректального рака и других заболеваний.
-
Нарушения всасывания
Изменения в составе и консистенции кала, например, жирный или блестящий стул, могут свидетельствовать о нарушениях всасывания питательных веществ, таких как при целиакии или хроническом панкреатите.
-
Функциональные нарушения
-
Хронический запор или диарея могут указывать на функциональные расстройства, такие как синдром раздраженного кишечника.
-
-
Нарушения микрофлоры
-
Изменение цвета, запаха и консистенции кала может свидетельствовать о дисбактериозе или изменениях в микрофлоре кишечника.
-
Как проходит процедура сдачи анализа?
Анализ кала обычно сдается утром. Для анализа используют небольшое количество кала (1-2 чайные ложки), собранное в специальный контейнер. Важно соблюдать правила гигиены при сборе материала и не допускать попадания мочи или воды в образец.

122
~1.5 мин









